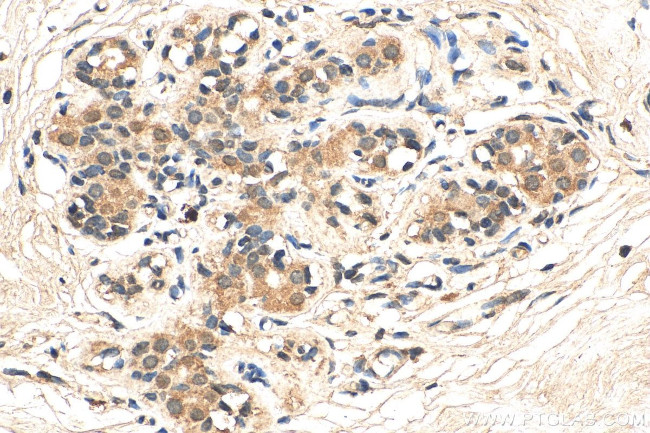
DDX3 Antibody in Immunohistochemistry (Paraffin) (IHC (P))

Search
Proteintech
DDX3 Monoclonal Antibody (1D3A1)
{{$productOrderCtrl.translations['antibody.pdp.commerceCard.promotion.promotions']}}
{{$productOrderCtrl.translations['antibody.pdp.commerceCard.promotion.viewpromo']}}
{{$productOrderCtrl.translations['antibody.pdp.commerceCard.promotion.promocode']}}: {{promo.promoCode}} {{promo.promoTitle}} {{promo.promoDescription}}. {{$productOrderCtrl.translations['antibody.pdp.commerceCard.promotion.learnmore']}}
产品信息
67915-1-IG150UL
种属反应
宿主/亚型
分类
类型
克隆号
偶联物
形式
浓度
纯化类型
保存液
内含物
保存条件
运输条件
靶标信息
The protein encoded by this gene is a member of the large DEAD-box protein family, that is defined by the presence of the conserved Asp-Glu-Ala-Asp (DEAD) motif, and has ATP-dependent RNA helicase activity. This protein has been reported to display a high level of RNA-independent ATPase activity, and unlike most DEAD-box helicases, the ATPase activity is thought to be stimulated by both RNA and DNA. This protein has multiple conserved domains and is thought to play roles in both the nucleus and cytoplasm. Nuclear roles include transcriptional regulation, mRNP assembly, pre-mRNA splicing, and mRNA export. In the cytoplasm, this protein is thought to be involved in translation, cellular signaling, and viral replication. Misregulation of this gene has been implicated in tumorigenesis. This gene has a paralog located in the nonrecombining region of the Y chromosome. Pseudogenes sharing similarity to both this gene and the DDX3Y paralog are found on chromosome 4 and the X chromosome. Alternative splicing results in multiple transcript variants.
仅用于科研。不用于诊断过程。未经明确授权不得转售。
篇参考文献 (0)
生物信息学
蛋白别名: ATP-dependent RNA helicase DDX3X; CAP-Rf; DBX; DEAD (Asp-Glu-Ala-Asp) box helicase 3, X-linked; DEAD (Asp-Glu-Ala-Asp) box polypeptide 3, X-linked; DEAD box protein 3, X-chromosomal; DEAD box, X isoform; DEAD/H (Asp-Glu-Ala-Asp/His) box polypeptide 3; DEAD/H (Asp-Glu-Ala-Asp/His) box polypeptide 3, X-linked; DEAD/H box-3; Helicase-like protein 2; HLP2
基因别名: CAP-Rf; DBX; DDX14; DDX3; DDX3X; HLP2; MRX102
UniProt ID: (Human) O00571
Entrez Gene ID: (Human) 1654, (Rat) 317335